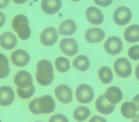

涉及型式
 肉毒桿菌分布
肉毒桿菌分布首先,只有專業的皮膚科醫生才可以完成這樣的手術,這不是美容院可以勝任的。這是因為肉毒桿菌套用在美容上,需要考慮很多的問題,比如劑量,注射的部位,這要經過專業的訓練,而一旦注射失敗,後果不亞於毀容。
其次,在注射的時候,還要經過非常嚴格的皮膚測試。作為一種毒性很強的桿菌,很多人對它會不適應,即使以前從未有過過敏現象的人,也可能會對它過敏。
當然,注射肉毒桿菌素以後,還需要不斷注射,才能讓效果延續,所以在經濟上需要一定的實力,注射肉毒桿菌素的費用大約是一次3000元左右。對於一些需要不斷動用表情的工作者來說,我們建議她在注射以後,最好有1~2周的時間是不工作的,否則會影響注射的效果。同時在注射以後,也不要做美容,特別是面部按摩,這樣也會降低注射的效果。
生存分布
肉毒桿菌在自然界分布廣泛,土壤中常可檢出,偶亦存在於動物糞便中。根據所產生毒素的抗原性不同,肉毒桿菌分為A、B、Ca、Cb、D、E、F、G這8個型,能引起人類疾病的有A、B、E、F型,其中以A、B型最為常見。
人體的胃腸道是一個良好的缺氧環境,適於肉毒桿菌居住。肉毒桿菌屬於厭氧菌,嚴格厭氧,在胃腸道內既能分解葡萄糖、麥芽糖及果糖,產酸產氣,又能消化分解肉渣,使之變黑,腐敗惡臭。在厭氧環境中,此菌能分泌強烈的肉毒毒素,能引起特殊的神經中毒症狀,致殘率、病死率極高。
肉毒桿菌芽胞抵抗力很強,乾熱180攝氏度5-15分鐘,濕熱100攝氏度5小時,高壓蒸氣121攝氏度30分鐘,才能殺死芽胞。肉毒毒素對酸的抵抗力特彆強,胃酸溶液24小時內不能將其破壞,故可被胃腸道吸收,損害身心健康。
致病機理
肉毒桿菌致病,主要靠強烈的肉毒毒素。肉毒毒素是已知最劇烈的毒物,毒性比KCN強一萬倍;純化結晶的肉毒毒素1mg能殺死2億隻小鼠,對人的致死劑量約0.1μg。肉毒毒素與典型的外毒素不同,並非由生活的細菌釋放,而是在細菌細胞內產生無毒的前體毒素,等待細菌死亡自溶後游離出來,經腸道中的胰蛋白酶或細菌產生的蛋白酶激活後方始具有毒性,且能抵抗胃酸和消化酶的破壞。
肉毒毒素是一種神經毒素,能透過機體各部的黏膜。肉毒毒素由胃腸道吸收後,經淋巴和血行擴散,作用於顱腦神經核和外周神經肌肉接頭以及植物神經末梢,阻礙乙醯膽鹼釋放,影響神經衝動的傳遞,導致肌肉的鬆弛性麻痹。
中毒症狀
攝食肉毒桿菌的食品可引發食物中毒 ,如 pH>4.6的低酸性罐頭食品(含鐵罐,玻璃罐) 或香腸、火腿 。人感染肉毒桿菌後會出現視覺模糊、呼吸困難、肌肉乏力等症狀,如病情嚴重可能導致死亡。
臨床表現:以神經系統症狀為主,胃腸道症狀不明顯,意識始終清醒。
①神經系統症狀:開始時出現頭暈(視物轉動)、頭痛、視物模糊,復視,全身無力,尤以頸部無力顯著,繼之有四肢麻木、舌硬、吞咽困難、嗆咳,進而發生各種肌群麻痹。
2消化系統症狀:多見便秘及腹脹,少數病人有噁心、嘔吐、腹痛及頻繁腹瀉等。
③其他:一般不發熱或微熱,脈搏先慢後快,重症可發生心力衰竭。唾液腺、汗腺分泌先多後少。
4嬰兒的肉毒中毒:多發生在6個月齡以內的嬰兒。其首發症狀為便秘,繼之出現神經麻痹,哭聲無力,動作困難伴肌張力減退,特別是肢體及頸部,眼肌麻痹,顏面表情呆滯,肛門括約肌張力減弱,可以突然出現呼吸停止。
臨床套用
毒素除皺
 肉毒桿菌臨床
肉毒桿菌臨床1992年有人嘗試將肉毒桿菌毒素注射除皺法引進到美容醫學的治療上,就是我們所說的除皺術。肉毒桿菌除皺術也稱為生物素除皺,肉毒桿菌A的商品名為“Botox”。
美容界這陣子的大熱門肉毒桿菌(Botox)可說是一種既不費時又不用開刀的整型治療,這讓許多愛美人士都躍躍欲試,
英國版ELLE報導,對於演藝娛樂界來說,任何的整容都已經過時,新世紀最流行的是自然的長相。
“肉毒桿菌素”是肉毒桿菌所分泌的毒素。它的作用是可以阻斷神經末梢分泌能使肌肉收縮的「乙醯膽鹼」,達到使肌肉麻痹的效果。
“肉毒桿菌素”,在美容方面,主要是用來去除動態的皺紋(如皺眉紋、魚尾紋、抬頭紋)及改善國字臉及蘿蔔腿。
祛皺原理
動態皺紋產生的原因:
常見的動態皺紋包括:額頭紋、魚眼紋、臉頰紋以及頸紋。常常我們會發現,在我們不做面部表情的時候,一般動態皺紋是無法體現的,而當笑臉或者是睜眼等其它面部肌肉活動的時候,就產生了動態皺紋。而出現這些情況的因素包括先天性因素、衰老、皮膚鬆弛以及後天性養成(例如痤瘡疤痕導致的面部紋理)。
去除動態皺紋的原理,是將收縮造成皺紋的肌肉麻痹掉,使肌肉不收縮,連帶的也去除了皺紋。一般在注射後三、四天就可以看到效果,一周后效果就很明顯。效用期約三至六個月,平均四個月。若皺紋再出現,視個人需要,可重複施打。
改善國字臉及蘿蔔腿的原理,是讓肥厚的肌肉不收縮,進而導致萎縮,達到瘦臉及瘦小腿的目的。一般可以在注射後二至三周看到效果,二至三個月效果最好。若需要則每半年注射一次,可達到很好的效果。
“肉毒桿菌素”若施打正確,是非常安全、有效的除皺及改善臉形、腿形的利器。
肉毒桿菌除皺術正是根據肌肉拉伸導致皺紋的原理,通過麻痹面部牽引的肌肉,從而達到除皺的目的。
特別注意:
單獨使用肉毒桿菌祛除動態皺紋,是不可能有良好效果的,必須配合玻尿酸、伊維蘭等填充才能真正達到完美的除皺效果。所以在注射肉毒桿菌的時候,一定要詢問醫師輔助填充治療,避免上當受騙。
除皺原因
傳言約翰克里的光滑額頭是肉毒桿菌的奇效,到底是怎么回事?肉毒桿菌毒素除皺法,是一項全新概念的除皺方法,人們認為“毒素”一定會對人體有傷害。但是恰恰相反,本法正是利用肉毒桿菌對面部表情肌肉的麻痹作用來達到減少皺紋的目的的。
最初發現肉毒桿菌是在1895年,到了1950年才開始將肉毒桿菌A套用於臨床,但僅限於治療神經肌肉亢進疾病。在美國,FDA已批准將其用於眼科、神經科和耳鼻喉科等有關肌肉亢進的疾病。1992年有人嘗試將其引進到美容醫學的治療上,就是所說的除皺術。”
適用範圍
“肉毒桿菌素”,在美容方面,主要是用來去除動態的皺紋,如皺眉紋、魚尾紋、抬頭紋,及改善國字臉及蘿蔔腿。若施打正確,是非常安全的,它可以有效除皺及改善臉形、腿形。
 肉毒桿菌可以除皺
肉毒桿菌可以除皺肉毒桿菌除皺術的適應症主要是治療早期皺紋,適用於35歲以下的女性,特別適用面上半部的額頭紋(抬頭紋)、眉間紋和眼眶周圍的魚尾紋,也可用於面部以下的下頦和前頸部皺紋。它的原理是,肉毒桿菌毒素作為一種神經毒素,注射於局部後能阻斷乙醯神經膽鹼的釋放,從而阻斷神經對肌肉的傳導。第一步毒素結合於神經原,進而進入神經細胞胞漿中,最後毒素抑制乙醯膽鹼作用於神經肌肉連線,使肌肉發生麻痹,這叫神經肌肉功能去神經。臨床上,通常注射2~3天出現肌肉運動的減弱。但最終軸突可萌芽形成新運動終板,同時無功能的運動單位被吸收,從而肌肉功能逐漸得以恢復。因此肉毒素注射的效果一般能維持3~6個月。
與其他手術一樣,它也有一些禁忌症,如妊娠、哺乳期婦女禁用;患有神經肌肉系統疾病如重症肌無力、多發性硬化等病禁用;患有上瞼下垂的病人禁用;服用氨基糖甙類抗生素的病人禁用;非常瘦弱的病人不用,因肌肉太薄注射後容易彌散到周圍肌肉發生副作用;對白蛋白或對肉毒桿菌毒素過敏的過敏體質的病人不用;患有嚴重心肝腎肺疾病和患有結締組織病的病人不能使用。
肉毒桿菌毒素注射除皺法療效非常顯著,通常注射肉毒桿菌毒素後,平均10天左右皺紋會慢慢地舒展、消失,皮膚變 平坦。除皺效果平均可維持3~6月,一般一年內要注射3~4次。魚尾紋效果最好,抬頭紋效果稍差。有人認為肉毒桿菌毒素注射將成為解除老年人除皺盲區的頸部皺紋最方便、有效的治療方法。
有人擔心注射肉毒桿菌毒素的安全性,可以肯定地回答肉毒桿菌毒素的注射是非常安全的,它對人的半致死量為40IU/Kg,一位體重50kg的病人其半致死量為2000IU,而用於美容除皺的劑量只是注射0.1~1ml液體5~50IU,所以注射肉毒桿菌毒素非常安全,不需住院,不需開刀,不影響上班。
副作用
肉毒桿菌來源於肉毒梭狀芽胞桿菌,它能抑制局部肌肉組織的神經信號。美容用的肉毒桿菌副作用較小,可能會引起短時的頭痛,眼部或嘴部鬆弛。但如果注射的肌肉組織錯誤的話,則可能會引起輕微的挫傷和流感病症。
儘管如此,肉毒桿菌毒素除皺還是有一定的併發症和副作用,如注射局部有頭痛;抬頭紋處注射不當時會發生瞼下垂;魚尾紋處注射不當時會發生復視及閉眼不全;因注射劑量不準確,一側多、一側少會發生不對稱的結果;進針刺破血管偶爾發生出血或血腫;大劑量、反覆注射可能會引起免疫複合物疾病;肌肉麻痹的結果是不能做各種表情,有假面具樣感覺;極少數病人可發生過敏性休克。
初次治療一星期後應對患者進行複查,此時的治療效果、併發症等就都很確切了。少數患者可能需要補充注射,由此就能確定對每一位患者的理想劑量。還有一些注意事項,如病人在注射前14天要停止使用阿司匹林和阿司匹林類藥物;注射當日要停用化妝品;注射後不要按摩局部,以免毒素擴散等。
已經有許多導演拒絕讓施打肉毒桿菌的演員上陣,因為雖然美得巧奪天工,但是肌肉已經僵硬,完全無法做出正常的喜怒哀樂表情。
十大致命毒藥
| 毒藥的正式研究開始於19世紀早期,標誌是生理學家克勞德伯納得研究馬錢子的藥效。 | |
| 肉毒桿菌 | 是一種生長在缺氧環境下的細菌,在罐頭食品及密封醃漬食物中具有極強的生存能力,是目前毒性最強的毒素之一。 |
| 蓖麻毒素 | 是一種具有兩條肽鏈的高毒性的植物蛋白。它主要存在於蓖麻籽中。由於其毒性強烈,診斷、治療困難,早在第一次世界大戰期間。 |
| 炭疽 | 是由炭疽桿菌所致的人畜共患傳染病。原系食草動物(羊、牛、馬等)的傳染病,人因接觸這些病畜及其產品或食用病畜的肉類而被感染。 |
| 沙林毒氣 | 是一種劇毒神經毒劑,通過過度刺激肌肉和重要器官影響神經系統產生致命效果。 |
| 河豚毒素 | 是一種能麻痹神經的劇毒,通常只需氰化鉀五百分之一就可置人於死地的劇毒,中毒的人會因神經麻痹而窒息而死,其中,毒素直接進入血液中毒死亡速度最快。 |
| 氰化物 | 可分為無機氰化物,有機氰化物,凡能在加熱或與酸作用後或在空氣中與組織中釋放出氰化氫或氰離子的都具有與氰化氫同樣的劇毒作用。 |
| 汞中毒 | 汞中毒(mercurypoisoning)以慢性為多見,主要發生在生產活動中,長期吸入汞蒸氣和汞化合物粉塵所致。以精神異常、齒齦炎、震顫為主要症狀。 |
| 士的寧 | 又名番木鱉鹼,是由馬錢子中提取的一種生物鹼,能選擇性興奮脊髓,增強骨骼肌的緊張度,臨床用於輕癱或弱視的治療。 |
| 鵝膏毒素 | 來自於一種毒蘑菇,它可在幾天之內摧毀人們的肝和腎,人們會清醒的感受到來自於身體的極度疼痛,直至昏迷、死亡。 |
| 毒鼠強 | 是德國科學家在1949年首次合成的,化學名稱為“四亞甲基二碸四胺”,其毒性極大,被實驗動物食入後,毒物未達到胃裡毒性便發作。 |
世界十大致命毒藥
| 毒藥的正式研究開始於19世紀早期,標誌是生理學家克勞德伯納得研究馬錢子的藥效。 | |
| 武器——大規模殺傷性武器>>>回到科學頻道 | |
| 肉毒桿菌 | 是一種生長在缺氧環境下的細菌,在罐頭食品及密封醃漬食物中具有極強的生存能力,是目前毒性最強的毒素之一。 |
| 蓖麻毒素 | 是一種具有兩條肽鏈的高毒性的植物蛋白。它主要存在於蓖麻籽中。由於其毒性強烈,診斷、治療困難,早在第一次世界大戰期間,美軍就將其作為侯選化學戰劑進行了廣泛研究,並曾生產了1700公斤的蓖麻毒素粗品。 |
| 炭疽 | 是由炭疽桿菌所致的人畜共患傳染病。原系食草動物(羊、牛、馬等)的傳染病,人因接觸這些病畜及其產品或食用病畜的肉類而被感染。 |
| 沙林毒氣 | 是一種劇毒神經毒劑,通過過度刺激肌肉和重要器官影響神經系統產生致命效果。 |
| 河豚毒素 | 是一種能麻痹神經的劇毒,通常只需氰化鉀五百分之一就可置人於死地的劇毒,中毒的人會因神經麻痹而窒息而死,其中,毒素直接進入血液中毒死亡速度最快。 |
| 氰化物 | 可分為無機氰化物,很多氰化物,凡能在加熱或與酸作用後或在空氣中與組織中釋放出氰化氫或氰離子的都具有與氰化氫同樣的劇毒作用。 |
| 汞中毒 | 汞中毒(mercurypoisoning)以慢性為多見,主要發生在生產活動中,長期吸入汞蒸氣和汞化合物粉塵所致。以精神異常、齒齦炎、震顫為主要症狀。 |
| 士的寧 | 又名番木鱉鹼,是由馬錢子中提取的一種生物鹼,能選擇性興奮脊髓,增強骨骼肌的緊張度,臨床用於輕癱或弱視的治療。 |
| 鵝膏毒素 | 來自於一種毒蘑菇,它可在幾天之內摧毀人們的肝和腎,人們會清醒的感受到來自於身體的極度疼痛,直至昏迷、死亡。 |
| 毒鼠強 | 是德國科學家在1949年首次合成的,化學名稱為“四亞甲基二碸四胺”,其毒性極大,被實驗動物食入後,毒物未達到胃裡毒性便發作,每1000克體重使用0.2毫克,幾分鐘即可死亡,且化學結構非常穩定,不易降解,可造成二次、三次中毒。 |
常見細菌門類分類導航
放線菌門| 衣原體門 | 藍藻門| 厚壁菌門| 變形菌門|世界十大致命毒藥全揭秘
| 人類發現毒藥是一種偶然,可能是在做飯的時候發現了某些植物含有劇毒。然而具有毒藥知識的人在那個時候被尊為是部落的術士。第一份下毒殺人的記錄出現在基督時代的羅馬帝國,但在之前,印度人、中國人、希臘人、埃及人早已開始使用毒藥。埃及豔后就用奴隸來實驗天仙子、顛茄和亞薩普蛇毒(最後其自殺所選用的蛇)。甚至在很多國家有人一點一點的增加毒藥的食用量,以達到對它們的免疫,例如在大仲馬筆下的《基度山伯爵》中有類似的描寫。人類歷史上發明和發現了數不清的毒藥,美國科學雜誌近日就評出了世界十大致命毒藥: |